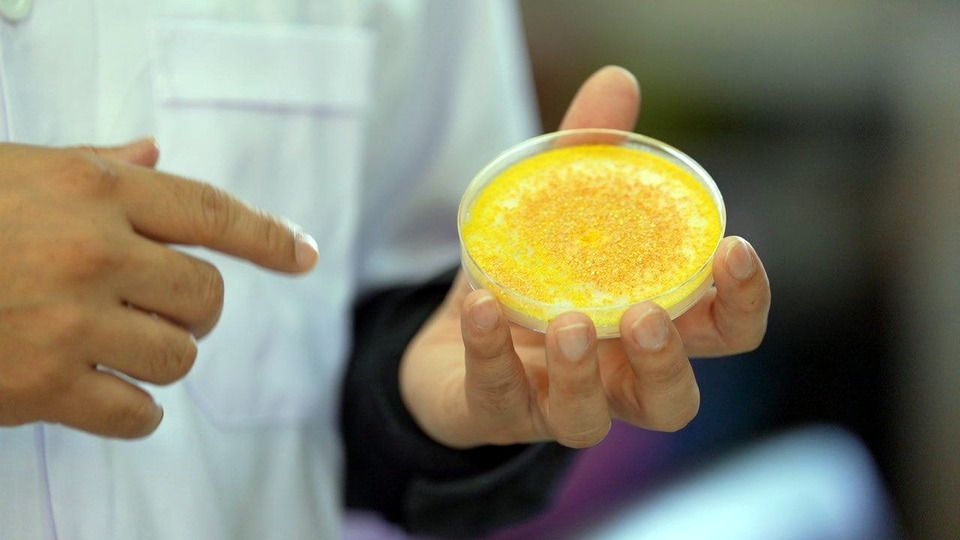

“ปุ๋ยชีวภาพละลายฟอสเฟต” ผลิตภัณฑ์ชั้นเลิศของ กลุ่มวิจัยปฐพีวิทยา กองวิจัยพัฒนาปัจจัยการผลิตทางการเกษตร กรมวิชาการเกษตร เพื่อพี่-น้องเกษตรกรไทย
ฟอสฟอรัส เป็นธาตุอาหารหลักที่มีบทบาทสำคัญต่อการเจริญเติบโตของพืช เนื่องจากฟอสฟอรัสเป็นองค์ประกอบของสารสำคัญหลายชนิดในกระบวนทางชีวเคมี เช่น deoxyribonucleic acid (DNA), ribonucleic acid (RNA), adenosine triphosphate (ATP), phospholipid และ coenzyme โดยพืชจะได้รับฟอสฟอรัสจากดินผ่านกระบวนการดูดซึมทางราก ในรูปของไอออนฟอสเฟตที่ละลายในน้ำ อย่างไรก็ตาม แม้ดินจะมีฟอสฟอรัสในปริมาณสูง แต่พืชสามารถดูดใช้ ได้เพียงร้อยละ 0.10 ของฟอสฟอรัสทั้งหมดในดิน เนื่องจากฟอสฟอรัสส่วนใหญ่อยู่ในรูปของสารประกอบที่ไม่ละลายน้ำ ส่งผลให้พืชไม่สามารถดูดใช้ได้โดยตรง
นอกจากนี้ เมื่อมีการใส่ปุ๋ยเคมีฟอสเฟตลงสู่ดิน ฟอสฟอรัสส่วนใหญ่จะทำปฏิกิริยากับแคทไอออนในดินเปลี่ยนไปอยู่ในรูปของสารประกอบที่ไม่ละลายน้ำ พืชจึงดูดซึมไปใช้ไม่ได้ กลายเป็นทรัพยากรที่ถูกทิ้งไว้อย่างเปล่าประโยชน์ จากข้อจำกัดดังกล่าว กรมวิชาการเกษตรจึงได้ศึกษากลไกตามธรรมชาติของระบบดิน–พืช จนพบว่าจุลินทรีย์กลุ่มที่เรียกว่า Phosphate Solubilizing Microorganisms (PSM) หรือจุลินทรีย์ละลายฟอสเฟต มีบทบาทสำคัญในการเปลี่ยนฟอสฟอรัสจากสารประกอบที่ไม่ละลายน้ำ ให้อยู่ในรูปของไอออนฟอสเฟตที่ละลายในน้ำ ทำให้พืชสามารถดูดใช้ได้อย่างมีประสิทธิภาพ

ดร.สนธยา ขำติ๊บ นักวิชาการเกษตรชำนาญการพิเศษ กลุ่มวิจัยปฐพีวิทยา กองวิจัยพัฒนาปัจจัยการผลิตทางการเกษตร กรมวิชาการเกษตร เปิดเผยว่า การพัฒนาผลิตภัณฑ์ปุ๋ยชีวภาพละลายฟอสเฟตเริ่มจากการคัดแยกจุลินทรีย์จากตัวอย่างดิน โดยเฉพาะบริเวณไรโซสเฟียร์ (rhizosphere) ซึ่งเป็นบริเวณรอบรากพืชที่มีการเจริญเติบโตดี จากนั้นนำจุลินทรีย์ที่คัดได้มาทดสอบประสิทธิภาพการละลายฟอสเฟตร่วมกับการปลูกพืช ทั้งในระดับห้องปฏิบัติการ ระดับกระถาง และระดับแปลงทดลอง เพื่อคัดเลือกสายพันธุ์ที่มีศักยภาพสูงสำหรับการผลิตเป็นปุ๋ยชีวภาพ จากการศึกษาพบแบคทีเรียในสกุล Bacillus, Burkholderia และ Pseudomonas รวมถึงราในสกุล Talaromyces, Penicillium และ Aspergillus ที่มีความสามารถในการผลิตและปลดปล่อย “กรดอินทรีย์” ออกมา ซึ่งกรดเหล่านี้เองที่ทำหน้าที่เหมือน "กุญแจ" ไปปลดล็อกฟอสเฟตที่ถูกตรึงในดิน ให้กลับมาอยู่ในรูปที่พืชสามารถดูดใช้เพื่อการเจริญเติบโตได้

จากองค์ความรู้ที่ได้จากงานวิจัยที่ผ่านมา กลุ่มวิจัยฯ ได้นำมาต่อยอดพัฒนาเป็นปุ๋ยชีวภาพละลายฟอสเฟตจากราสกุล Talaromyces ซึ่งมีศักยภาพในการเพิ่มความเป็นประโยชน์ของธาตุฟอสฟอรัสในดิน ทำให้พืชสามารถดูดใช้ได้อย่างมีประสิทธิภาพ ส่งผลต่อการส่งเสริมการเจริญเติบโตของพืช อีกทั้งราสกุล Talaromyces ที่สามารถเจริญได้ในสภาพความเป็นกรด-ด่าง 4-10 ดังนั้นจึงสามารถมีชีวิตรอดและมีกิจกรรมการละลายฟอสเฟตได้ในสภาพแปลงปลูกพืชทั่วประเทศ
นอกจากนี้ทางกลุ่มวิจัยฯ ยังคงมุ่งมั่นวิจัยพัฒนาเพื่อพัฒนาปุ๋ยชีวภาพละลายฟอสเฟตรูปแบบใหม่ ๆ เพื่อให้สอดคล้องกับการใช้งานของเกษตรกร เพื่อความยั่งยืนของทั้งเกษตรกร ผู้บริโภค และสิ่งแวดล้อม ที่พร้อมปลดล็อกพลังจากดิน คืนชีวิตให้ผลผลิต ด้วยนวัตกรรมปุ๋ยชีวภาพละลายฟอสเฟต

สอบถามข้อมูลเพิ่มเติมได้ที่หน่วยงานของกรมวิชาการเกษตร กลุ่มวิจัยปฐพีวิทยา กองวิจัยพัฒนาปัจจัยการผลิตทางการเกษตร กรมวิชาการเกษตร โทรศัพท์ 0-2579-7522-3, 0-2579-4116 E-mail: soilscience2560@gmail.com







